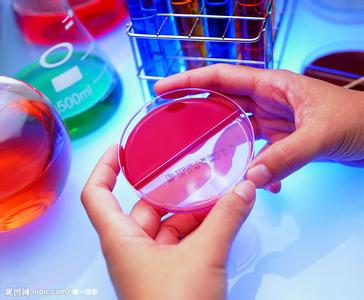

科學研究
為城市軌道交通工程建設、運營及其環(huán)境、安全保障等的提供的各種攻關性、前瞻性等科學研究和技術研發(fā)工作,主要包括:關鍵技術研究、技術標準制定、產品研發(fā)推廣、發(fā)展戰(zhàn)略研究、法規(guī)政策研制。內容涉及:風險管理、安全保障、應急管理、客流仿真、預警系統(tǒng)、風險標準、體系辦法、系統(tǒng)集成等方面。截止目前,我公司已主編地方標準1部、參編國家和地方標準6部,參與制定政策性文件3部,主持或參與各類課題研究30余項,完成產品研發(fā)10余項。榮獲省部級科學技術獎一等獎2項、三等獎1項,城建集團科技進步一等獎1項、二三等獎多項;申報有10多個軟件著作權、1個實用新型專利、3個發(fā)明專利。





 版權所有? 2014 安捷工程咨詢有限公司 地址:北京市西城區(qū)珠市口西大街105號8幢二層202室
版權所有? 2014 安捷工程咨詢有限公司 地址:北京市西城區(qū)珠市口西大街105號8幢二層202室 